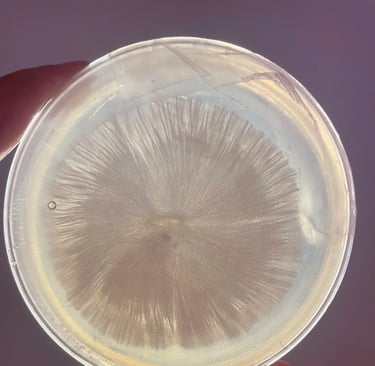
Mycélium de Psilocybes Cubensis avec une croissance rhizomorphique sur gélose

À propos de Neurocybine : Expertise en Psilocybine et Accompagnement Psychédélique Personnalisé

Une démarche née de l’exploration et de la conviction
Neurocybine n’est pas née d’une logique commerciale, mais d’un constat partagé.
Au fil des années, à travers des expériences personnelles et une observation approfondie, une évidence s’est imposée : lorsqu’elle est abordée avec sérieux, dans un cadre adapté et avec un accompagnement rigoureux, la psilocybine peut ouvrir des espaces de compréhension et de transformation durables.
Ce constat ne repose pas sur une promesse, mais sur une expérience vécue, répétée et analysée dans le temps.
C’est à partir de cette conviction qu’Ilias et Myriam ont choisi de créer Neurocybine : un cadre structuré, exigeant et accessible, pensé pour proposer une approche plus rigoureuse, loin des dérives approximatives ou purement récréatives, et adaptée à un public francophone dans le respect du cadre légal.
Les fondateurs de neurocybine.
Ilias – Mycologue Co-fondateur & Accompagnateur
Il y a dix ans, Ilias découvre la psilocybine et entreprend d’en comprendre en profondeur les effets et le potentiel. Passionné par la mycologie et le monde des champignons, il aborde rapidement ces explorations avec une approche rigoureuse, cherchant à dépasser les idées reçues pour observer concrètement ce qui se joue dans ces états modifiés de conscience.
Au fil des années, il accumule plus d’une trentaine d’expériences personnelles, vécues dans des contextes variés et à travers différents niveaux de dosage, avec une attention constante portée à l’observation, à l’intégration et à la compréhension des mécanismes à l’œuvre.
Cette diversité d’explorations lui permet aujourd’hui d’avoir une compréhension fine des dynamiques propres à l’expérience, ainsi que de ses variations selon les contextes et les intensités.
Ces explorations ont également joué un rôle direct dans son propre parcours, notamment face à certains schémas de pensée persistants, à des périodes plus difficiles, ou à des questionnements profonds.
Avec le temps, cette démarche s’élargit au contact d’autres personnes. Il constate des évolutions tangibles : prise de recul face à certains comportements, apaisement progressif de certains états, et transformation durable du rapport à soi et aux situations. C’est cette double approche, à la fois personnelle et analytique, qui a donné naissance à Neurocybine.
Aujourd’hui, Ilias poursuit ses travaux en mycologie et en sélection de souches, avec une attention particulière portée à la stabilité, à la qualité et à la reproductibilité des expériences proposées. Il collabore également avec des partenaires à l’international dans une logique d’amélioration continue.
Mais au-delà des aspects techniques, son rôle repose avant tout sur l’accompagnement de l’expérience elle-même : comprendre ce qui se joue en temps réel, ajuster sa présence, et offrir un cadre structuré permettant à chacun de vivre pleinement son processus.
“Je sais ce que traversent nos participants, parce que j’ai moi-même exploré ces états à de nombreuses reprises, sous différentes intensités. C’est cette expérience directe qui guide ma manière d’accompagner.”
Myriam – Co-fondatrice & Accompagnatrice
C’est dans le cadre de son activité dans le secteur médical que Myriam découvre la psilocybine, au moment où les premières études cliniques commencent à émerger. Elle s’y intéresse avec attention, dans une démarche d’observation et de compréhension.
Il y a sept ans, elle vit sa première expérience. Elle en retient une clarté inhabituelle, une perception différente de certaines situations, et un apaisement qui s’installe progressivement dans les jours qui suivent. Une expérience marquante, à la fois subtile dans sa forme et profonde dans ses effets.
Au fil des années, elle réalise plus d’une dizaine d’expériences psychédéliques, avec une approche volontairement mesurée. Elle accorde une attention particulière aux dosages légers et intermédiaires, souvent sous-estimés, mais qui révèlent une finesse et une richesse spécifiques dans le travail intérieur.
Ce parcours lui permet de développer une compréhension concrète des dynamiques vécues pendant l’expérience, ainsi que des transformations qui peuvent s’inscrire dans le temps.
C’est au cours de ce cheminement qu’elle rencontre Ilias. Deux approches différentes, mais une même exigence : proposer un cadre sérieux, adapté et respectueux de ce que ces expériences impliquent réellement. Neurocybine s’est construit à partir de cette convergence.
Aujourd’hui, Myriam joue un rôle central dans l’accompagnement des participants. Sa capacité à percevoir les états émotionnels, à ajuster sa présence avec précision, et à intervenir uniquement lorsque cela est nécessaire en fait un repère essentiel, notamment dans les moments les plus sensibles.
Elle incarne une forme d’accompagnement où la présence prime sur l’intervention, et où la justesse compte plus que l’intensité.
“Être présent pour quelqu’un dans ces moments-là demande plus que de la bienveillance. Cela demande de l’expérience, de la stabilité et une capacité réelle à s’ajuster à ce qui se passe, sans projeter ni interpréter à la place de l’autre.”


Notre approche : personnalisée, encadrée, éthique
Une expérience avec la psilocybine ne s’improvise pas. Ce qui se joue avant, pendant et après la session est aussi important que l’expérience elle-même. C’est sur ce principe que repose l’ensemble de notre accompagnement.
Notre approche s’inscrit dans un cadre non médical, laïque et structuré, sans dimension spirituelle, et ne se substitue en aucun cas à un suivi thérapeutique. Elle vise à offrir un espace structuré d’exploration et d’intégration, dans le respect du parcours de chacun.
Adaptation
Chaque parcours débute par un temps d’échange approfondi. Nous prenons le temps de comprendre votre situation, vos attentes et vos éventuelles contre-indications, afin de déterminer si notre accompagnement est réellement adapté à ce que vous traversez.
Les protocoles, les dosages et le cadre sont ensuite ajustés en conséquence. Rien n’est standardisé. Chaque expérience est pensée pour être cohérente avec la personne et le moment de vie dans lequel elle se trouve.
Cadre
L’environnement dans lequel se déroule l’expérience n’est pas un détail. Un cadre stable, sécurisé et maîtrisé permet de limiter les perturbations et de favoriser un engagement plus profond dans le processus.
Chaque élément est pensé et adapté avec soin : la musique, le rythme de la session et les conditions dans lesquelles elle se déroule.
Ce cadre ne contraint pas l’expérience, il crée les conditions pour qu’elle puisse se déployer pleinement.
Dans certains cas, notamment pour les sessions privées, ce cadre peut être défini avec le participant et adapté à son lieu d’hébergement, afin de favoriser un environnement familier et propice au lâcher-prise.
Accompagnement
Notre rôle n’est pas de diriger l’expérience, mais de la soutenir avec justesse. Nous sommes présents de manière continue, du début à la fin, avec une attention constante portée à ce qui se joue.
Cette présence s’adapte à chacun. Certains participants ont besoin d’être guidés et soutenus de près. D’autres, au contraire, ont besoin d’espace et d’intimité pour laisser leur processus se déployer librement.
Observer, comprendre les dynamiques émotionnelles et ajuster notre position en temps réel, sans jamais interférer inutilement : c’est cet équilibre qui permet à chacun de vivre pleinement son expérience, dans un cadre à la fois solide et respectueux.
L’expérience ne s’arrête pas à la session. Des échanges sont proposés dans les jours et semaines qui suivent, afin d’accompagner ce qui émerge et de favoriser une intégration durable.

La mycologie au service de l’expérience
Toutes les truffes et tous les champignons à psilocybine ne présentent pas les mêmes caractéristiques. Leur teneur en composés actifs, notamment la psilocybine, la psilocine et d’autres alcaloïdes, peut varier significativement, tout comme leur stabilité de cette concentration d’un lot à l’autre.
Ces variations influencent non seulement l’intensité de l’expérience, mais aussi sa progression, et sa lisibilité. La qualité et la stabilité d’une souche deviennent alors des éléments déterminants dans la manière dont l’expérience se déploie.
Un travail rigoureux en mycologie permet de mieux maîtriser ces paramètres. En développant et en sélectionnant des souches plus homogènes dans leur profil, il devient possible d’ajuster plus finement les quantités ingérées. Des concentrations plus élevées permettent notamment de réduire le volume de matière nécessaire, ce qui peut contribuer à limiter certains inconforts digestifs associés à l’ingestion.
De la même manière, une meilleure stabilité dans la composition offre une base plus cohérente pour adapter les dosages et proposer des intensités mieux ajustées aux profils et aux contextes, tout en conservant une part inhérente de variabilité propre à ce type d’expérience.
C’est dans cette logique qu’Ilias a consacré plusieurs années à la sélection et au développement de souches exclusives, issues d’un travail progressif fondé sur l’observation, l’expérimentation et l’amélioration continue. Ces souches ne sont pas achetées sur catalogue, mais développées avec une attention particulière portée à leur qualité, leur cohérence et leur adéquation avec les protocoles proposés.
L’objectif n’est pas de standardiser l’expérience, mais d’en comprendre les variations afin de proposer des cadres plus justes et adaptés à chaque profil.




Le savoir-faire d’encadrement : ce que l’expérience seule permet de développer
Comprendre la psilocybine sur le plan théorique ne suffit pas pour accompagner une personne dans les moments les plus intenses d’une expérience. Ce qui fait la différence se construit ailleurs : dans l’expérience directe, répétée, et dans la confrontation à la réalité de ce qui se joue, session après session.
Au fil des années, à travers des explorations personnelles menées dans des contextes variés, puis dans l’accompagnement de nombreux participants, une compréhension plus fine s’est progressivement développée. Non pas une compréhension abstraite, mais une lecture concrète des dynamiques à l’œuvre : les phases de montée, les résistances, les bascules, les moments de lâcher-prise, ou au contraire les blocages.
Reconnaître ces états ne suffit pas. Il s’agit aussi de savoir comment s’y positionner. Quand intervenir. Quand se taire. Quand soutenir. Quand laisser l’expérience suivre son propre cours.
Cette justesse ne s’improvise pas. Elle se construit avec le temps, à travers l’observation, l’attention portée aux détails, et une remise en question constante de sa propre posture.
Elle implique également de savoir rester stable face à des états parfois intenses, sans projeter, sans interpréter, et sans chercher à orienter ce qui se vit.
C’est ce savoir-faire, à la fois discret et exigeant, qui permet aujourd’hui d’offrir un accompagnement structuré, capable de s’adapter à chaque situation sans jamais imposer de lecture ou de direction.
Chaque expérience est unique, à l’image de la personne qui la vit. Les ressentis, les prises de conscience et les évolutions possibles varient selon le parcours, le contexte et la manière dont l’expérience est abordée.
Chez Neurocybine, nous ne promettons pas de résultat. Nous nous engageons à proposer un cadre structuré, sécurisé et éthique, permettant à chacun de vivre une expérience cohérente, dans le respect de son propre rythme.
Chaque expérience ouvre des possibilités. Ce qui compte, c’est ce qui en est fait ensuite.

Neurocybine BV
Herengracht 420,
1017BZ AMSTERDAM
Pays-Bas
KvK : 94861986
contact@neurocybine.com
+31 (0)2.03.23.36.88
Politique de réservation et d'annulation
site hébergé par Hostinger International Ltd.
© 2024 – 2026 Neurocybine. Tous droits réservés.
